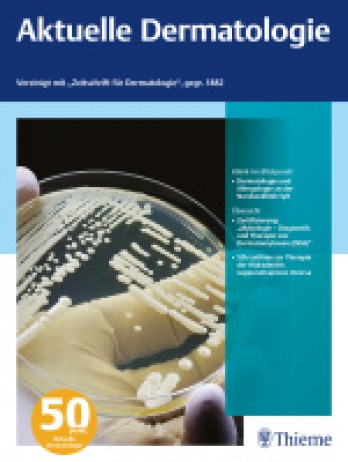

《Aktuelle Dermatologie》國際標(biāo)準(zhǔn)刊號?ISSN:0340-2541,電子期刊的國際標(biāo)準(zhǔn)刊號:1438-938X。
出版語言:English
國際簡稱:AKTUEL DERMATOL
研究方向:DERMATOLOGY
期刊定位與內(nèi)容:
當(dāng)前皮膚科(Aktuelle Dermatologie)是一本由Thieme出版的學(xué)術(shù)刊物,主要報道DERMATOLOGY相關(guān)領(lǐng)域研究成果與實踐。本刊已入選來源期刊,
《當(dāng)前皮膚科雜志》作為語言學(xué)研究的重要平臺,自創(chuàng)刊以來,一直致力于推動語言學(xué)理論的探索、語言現(xiàn)象的分析以及語言教學(xué)方法的創(chuàng)新。該雜志由具有深厚學(xué)術(shù)背景和廣泛影響力的機構(gòu)出版,確保了其內(nèi)容的權(quán)威性和前沿性。該雜志涵蓋了語言學(xué)的多個子領(lǐng)域,包括但不限于語音學(xué)、音系學(xué)、句法學(xué)、語義學(xué)、語用學(xué)、語言習(xí)得、語言類型學(xué)、歷史語言學(xué)、社會語言學(xué)以及應(yīng)用語言學(xué)等,為讀者提供了豐富的學(xué)術(shù)資源。該雜志在語言學(xué)界享有較高的聲譽和影響力,其發(fā)表的論文經(jīng)常被其他學(xué)術(shù)期刊引用,為語言學(xué)研究的發(fā)展做出了重要貢獻。
發(fā)文量:
近年來,該期刊的年發(fā)文量約為27篇。
學(xué)術(shù)影響力:
2021-2022年最新版WOS分區(qū)等級:Q4,2023年發(fā)布的影響因子為0.1,CiteScore指數(shù)0.3,SJR指數(shù)0.109。本刊非開放獲取期刊。
Cite Score(2024年最新版)
- CiteScore:0.3
- SJR:0.109
- SNIP:0.043
| 學(xué)科類別 | 分區(qū) | 排名 | 百分位 |
| 大類:Medicine 小類:Dermatology | Q4 | 127 / 142 |
10%
|
CiteScore:該指標(biāo)由Elsevier于2016年提出,指期刊發(fā)表的單篇文章平均被引用次數(shù)。CiteScorer的計算方式是:例如,某期刊2022年CiteScore的計算方法是該期刊在2019年、2020年和2021年發(fā)表的文章在2022年獲得的被引次數(shù),除以該期刊2019年、2020年和2021發(fā)表并收錄于Scopus中的文章數(shù)量總和。
聲明:本信息依據(jù)互聯(lián)網(wǎng)公開資料整理,若存在錯誤,請及時聯(lián)系我們及時更正。